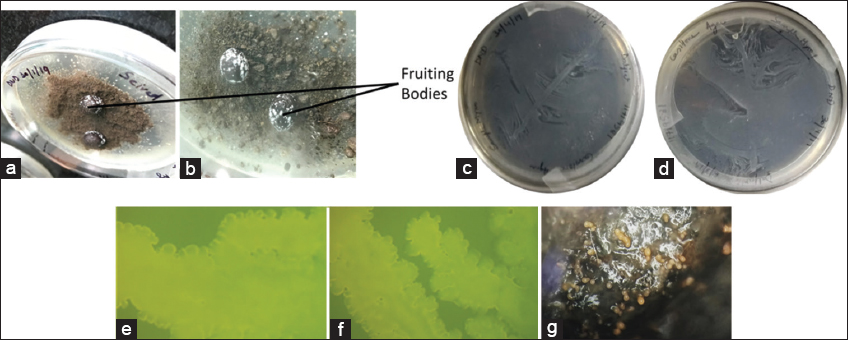
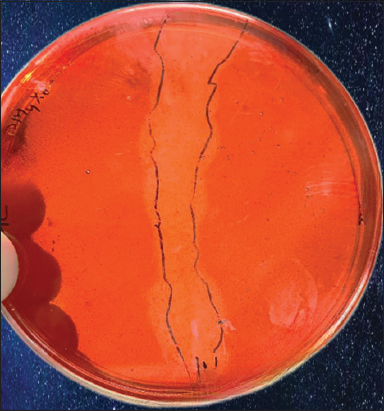

1. INTRODUCTION
Today, different industries are progressing at an alarming rate and continuously demanding the discovery of new bioactive molecules to meet the demand of biotechnology industries [1]. Owing to challenges associated with plants and animal sources, microbes have become the favorite source for industrial enzymes, as the enzymes obtained economically from animals and plants are limited, while the progressive development in fermentation technology has assured an unlimited economic supply of microbial enzymes [2]. Therefore, the researchers have shifted their interest toward microbes, which are major natural producers of bioactive molecules such as enzymes, antibacterial agents, polyketides, antihelminthics, anti-parasitic, and immunosuppressive agents [3-5]. However, antibiotic resistance and diverse environmental conditions have prompted researchers to explore untapped microbes such as endosymbionts, myxobacteria, cyanobacteria, and marine bacteria for obtaining functional bioactive molecules [6].
Myxobacteria is a member of the δ-proteobacteria family and unicellular aerobic, rod-shaped gram-negative bacteria, niching in a broad range of habitats such as decaying plants, tree bark, marine, and freshwater [7]. These species are known for producing unique fruiting bodies under nutrient-deficit conditions. Enormous myxobacteria are known to prey on microbes and use them as a nutrient source for multicellular development and growth; whereas few synthesize lytic enzymes for the degradation of macromolecules such as agar, chitin, and cellulose [8]. In contrast to other bacteria, myxobacteria have a large genome size [9]. According to the published literature, myxobacteria synthesize unique bioactive molecules acting on individual cellular targets. It is known to produce various secondary metabolites such as aurafurons, cyrmenins, crocacin, coralmycins, disciformycins, thuggacins, indiacens, and pedein, which exhibit antibacterial and anti-fungal activity [10]. FDA approved an analogue of epothilone B named ixabepilone in 2017 for cancer treatment [11]. Further, they are also known for the production of anti-viral compounds [12], diverse polyunsaturated fatty acids [13,14], steroids [15], and compounds that exhibit insecticidal activity [16]. In the past year, the isolation and discovery of novel species have expanded our understanding of myxobacterial biology and secondary metabolites. A few myxobacterial isolates have been regarded as facultative anaerobe [17], micro-aerotolerant [18], microaerophile [19,20], halotolerant [21], and obligate halophile [22].
Even though myxobacteria hold great potential and are an attractive source of unique and new chemical compounds; they are still not fully explored for isolating novel secondary metabolites because their isolation, as well as purification, is difficult as they are prone to lysis and sensitive to mechanical stress [23,24]. Concerning the immense potential of myxobacteria for synthesizing unique secondary metabolites and no report from the Union Territory of Jammu and Kashmir wetland, the present study was conducted on the wetland to isolate myxobacteria and assess it for synthesizing important industrial bioactive molecules. Since cellulose-degrading myxobacteria have industrial importance due to their application in different industrial sectors involving agriculture, biofuel, brewing, food industry, laundry, medical, paper and pulp, and textile industries [8,25]. Cellulase enzyme is employed in the textile sector for cotton softening and denim finishing, color care in the detergent business, and fiber modification and drainage improvement in the paper and pulp industry [26].
Thus, the current study was conducted to isolate and identify the myxobacteria species from the Mirgund Wetland of the Union Territory of Jammu and Kashmir based on their growth pattern and sequencing by 16s recombinant DNA (rDNA). Further, the isolated strain was screened for cellulase production and evaluated for optimum temperature and pH.
2. MATERIALS AND METHODS
2.1. Collection of Sample
Soil samples were collected from “Mirgund Wetland” (altitude of 1585 m at 34°10’ N latitude, 74°50’ E longitude) in the Kashmir Valley. The soil was excavated to a depth of roughly 5 cm before sample collection. The collected soil was transferred into a sterilized zip-lock bag and sealed. The sample was stored at 4°C for microbial analysis.
2.2. Physico-chemical Analysis of Soil
2.2.1. Determination of the pH of the soil
The pH of the soil was determined by dissolving 10 g of soil sample in 50 mL of deionized water. The suspension obtained was stirred after regular intervals for 30 min before the assessment; the pH meter was calibrated using the pH buffer at pH 4.0 and 6.86, respectively. After calibration, the pH electrode was immersed in soil suspension, and the value was recorded till the equilibrium was attained [27].
2.2.2. Determination of moisture content of the soil
For the assessment of the moisture content of the soil, first, the container was cleaned, dried, and weighed to one decimal point, i.e., W1. Then, 50 g of soil was placed in the container and weighed to one decimal point, i.e., W2. After weighing, the container was placed in the oven at 110°C for 16 h. After drying, the container was transferred to a desiccator and allowed to cool down. After cooling, the container was weighed with the soil sample to one decimal point, i.e., W3. To calculate the moisture content, the following formula was used:
 |
2.2.3. Isolation of myxobacteria
Isolation of myxobacteria was carried out using the dung-baiting Method, in which Petri plates were filled with Casitone media (tryptone [0.5 g/100 mL], peptone [0.1 g/100 mL], and 2% agar) and soil was moistened with distilled water containing (25 mg/mL) cycloheximide. Autoclaved and dried goat dung pellets were embedded in each plate, leaving about half of the pellet protruding from the soil. Then, the plates were incubated at 28°C for 7–14 days and were observed for white patches on the goat dung pellet [24].
2.2.4. Sub-culturing and screening of myxobacteria
The white patches signifying the migrated myxobacteria were picked from the goat dung pellet and inoculated in test tubes containing Casitone broth. It was incubated for 7–10 days at 28°C at 150 rpm and was observed for whitish-yellow-colored rings. The culture was taken from the whitish-yellow-colored ring for screening and streaked as one single line on the Casitone media plate. Then, the plates were incubated at 28°C for 7 days. After that, the plates were observed for swarm growth (under a stereomicroscope), as suggested previously [7].
2.2.5. Isolation of genomic DNA and amplification
Genomic DNA isolation was carried out from the cultures raised in Casitone broth for approximately 48 h, further following the protocol stated by Green and Sambrook [28]. After genomic DNA isolation, it was assessed through gel electrophoresis on 0.8% agarose gel to assess DNA quality. After confirmation, polymerase chain reaction (PCR) amplification through 16S ribosomal RNA (rRNA) universal primers was done. The PCR reaction mixture that contains 7 μL of molecular grade water (HiMedia), 2.5 μL of the Taq polymerase ×10 buffer, 5 μL of the diluted template DNA, 2.5 μL of the dNTP mix (10 mM), and 1μL of each 27F (5’- AGAGTTTGATCCTGGCTCAG-3’) and 1492R (5’-GGTTACCTTGTTACGACTT-3’) universal primers were used. This reaction was then incubated in a DNA thermal cycler (Applied Biosystems), and the amplification conditions were set as follows: Pre-denaturation step at 95°C for 2 min, followed by 35 cycles (denaturation step for 30 s at 95°C, annealing for 50 s at 50°C, and extension for 1 min 45 s at 72°C) and final extension for 8 min at 72°C. After amplification, the 10 μL amplicon was subjected to electrophoresis on 1.2% agarose gel in ×1 TAE buffer for 1 h. After electrophoresis, the amplified DNA was visualized on Gel-Doc, and the amplicon was sent for sequencing analysis to Biologia Research India Pvt. Ltd, Delhi.
2.2.6. Isolation, amplification, and molecular characterization of genomic DNA
The obtained sequencing result was then analyzed using the Basic Local Alignment Search Tool (BLAST) tool for similarity search. Further, the phylogenetic tree was constructed using MEGA11 [29].
2.2.7. Primary and secondary screening for cellulase production
The pure isolate, i.e., MyxoMir001, was then further screened for cellulase production through the Congo Red-NaCl staining procedure to check for the zone of cellulose hydrolysis. In addition, secondary screening was done to assess enzyme localization. The isolate was cultured for 3–4 days in 0.1% CMC-supplemented Casitone broth. The media was subjected to centrifugation to remove the growth media. Then, the supernatant was collected, while the pellet was mixed with lysis buffer and glass beads. After mixing lysis buffer and glass beads, the sample was subjected to homogenization by vortex shaking. Then, cell lysate was centrifuged at 10,000 rpm for 10 min to obtain the cell-free extract [30].
Further, enzyme localization was assessed through the 3,5-dinitrosalicylic acid (DNS) method, where CMC was used as a specific substrate. The reaction mixture were prepared, which comprised 500 µL of phosphate buffer, 450 µL of the substrate (1% CMC), and 50 µL of the enzyme, which were used and incubated in the water bath for 30 min at 50°C. To determine the localization, the amount of reduced sugar formed was determined by adding 1 mL of DNS into a tube along with control (containing 950 μL of the substrate (1% CMC) and 50 μL of the enzyme, without incubation) which were placed in a water bath at 100°C for 15 min and finally cooled for 20 min using ice water. After cooling, absorbance was measured at the wavelength of 550 nm [31]. One unit of enzyme activity is stated for the amount of enzyme required to form 1 mL of product per unit time for each milliliter of the enzyme.
2.3. Biochemical Characterization of Cellulase Enzyme
2.3.1. Determination of optimum temperature
The optimum temperature was determined by assessing the enzyme activities at different temperatures ranging from 30 to 60°C. The tubes containing the reaction mixture (containing 500 μL of phosphate buffer, 450 μL of the substrate (1% CMC), and 50 μL of enzyme) were incubated at 10°C difference in different water bath ranging from 30 to 60°C for 30 min. After 30 min incubation at different temperatures, tubes were subjected to 100°C for 5 min and cooled to room temperature. The enzyme activity was assessed on cooling down using standard DNSA protocol [30].
2.3.2. Determination of optimum pH
The optimum pH was determined by assessing the enzyme activity at different pH values from 5 to 12. This range of pH values was chosen based on the sample pH’s determination during the sample’s physicochemical characterization and by referring to the previously published literature [30,32]. The tubes containing the reaction mixture (containing 500 μL of other buffers, i.e., citrate buffer (100 mM, pH 3–6), phosphate buffer (100 mM, pH 7), mM Tris-HCl buffer (100 mM, 8 to 10), and glycine-NaOH buffer (100 mM, pH 11–12), 450 μL of the substrate (1% CMC), and 50 μL of enzyme) were incubated at 10°C difference in different water bath ranging from 40°C for 30 min. After 30 min incubation, tubes were subjected to 100°C for 5 min and cooled to room temperature. The enzyme activity was assessed on cooling down using standard DNSA protocol [30].
3. RESULTS AND DISCUSSION
3.1. Physico-chemical Analysis of Soil
The pH and moisture content of the Mirgund soil were determined to be 8.0 and 33.8%, respectively. This pH condition aligns with the literature stating that the majority of myxobacteria isolated from soil fall within a pH range of 6.5–8.5 [33,34]. In 1997, Hook reported on the isolation of 10 different species such as Archangium gephyra, Myxococcus coralloides, Myxococcus disciformis, Myxococcus stipitatus, Myxococcus fulvus, Myxococcus virescens, Myxococcus xanthus, Melittangium lichenicola, Polyangium cellulosum, and Polyangium sorediatum from waters of an alkaline bog and adjacent soil having pH within the range of 6.0–8.7 [35]. Rückert reported on the isolation of two species of the Myxobacteria, i.e., Myxococcus virescens and M. stipitatus, from the soil of King George Island in the Antarctic with pH within the range of 5.7–6.9 [36] The previous studies also discuss the distribution of myxobacteria species in acidic soil (pH 3.7) as well as alkaline soil (pH 8.0–9.2) [37].
3.2. Isolation, Purification, and Taxonomy of Myxobacteria
Two pure strains of myxobacteria were isolated from Mirgund soil using the dung-baiting method. After 1 week of incubation, white patches were observed on the dung pellets. After observation, these patches were collected and inoculated in Casitone broth, which showed a yellow ring on the wall of a glass tube. This ring formation provided us with two strains of myxobacteria, i.e., MyxoMir001 and MyxoMir002. Both MyxoMir001 and MyxoMir002 showed the typical characteristic of myxobacteria, such as swarming patterns and fruiting body formation, confirming that these strains belong to the myxobacterial clan, as depicted in Figure 1. Moreover, Gram staining was also done to verify that these strains were Gram-negative. The observation of swarming patterns and fruiting bodies formation under nutrient-deficient conditions over water agar at ×4 magnification under stereomicroscope showed the similarity of morphological and growing pattern characteristics as stated in the literature related to myxobacteria isolated from the diverse geographical region [7,38-40]. In 2007, Wu et al. [41] studied the rapid swarming pattern of M. xanthus. They provided proof by developing a model explaining the contribution of S motility and A motility during the swarming of myxobacteria [41]. In 2007, Thakur et al. [7] reported the swarming pattern of myxobacterial strains when plated on the water agar plates with cycloheximide (25 mg/mL), which were isolated from soil of the Himachal Region [7].
| Figure 1: Migration of myxobacteria on dung pellets (a and b); (c and d) showing swarm pattern of myxobacteria on Casitone agar plates; and microscopic view of swarming growth (e) MyxoMir001, (f) MyxoMir002 observed under Stereomicroscope at ×4, (g) fruiting bodies of MyxoMir001 on dung pellets. [Click here to view] |
3.3. Isolation, Amplification, and Molecular Characterization of Genomic DNA
The genomic DNA was isolated from both strains following the protocol [28]. Further, the genomic DNA of isolated strains [Figure 2] was run on the 0.8% agarose gel and subjected to amplification using 16S rDNA primers (27F and 1492R). Genomic DNA of both MyxoMir001 and MyxoMir002 was used as the template for the DNA amplification. The amplified DNA was visualized on 1.2% agarose gel [Figure 2]. On obtaining the 16S rRNA gene sequence of both myxobacterial strains, the MyxoMir001 sample showed similarity with Myxococcus spp. (100%) using BLAST (multiple sequence alignment tool by the National Center for Biotechnology Information [NCBI]), which was further subjected to phylogenetic analysis. The sequence was submitted to the NCBI Database with an accession number OQ121678. The phylogenetic tree was constructed using MEGA11 [Figure 3] using the maximum likelihood method and the Hasegawa-Kishino-Yano model [42]. Initial tree(s) for the heuristic search were attained automatically by applying Neighbor-Join and BioNJ algorithms to a matrix of pair-wise distances determined using the maximum composite likelihood approach and then selecting the topology with superior log likelihood value (−2187.11). The tree was drawn to scale, with branch lengths measured in the number of substitutions per site.
 | Figure 2: (i) 0.8% agarose gel showing isolated genomic DNA of myxobacteria (L = Ladder, (a) DNA of MyxoMir001 and (b) DNA of MyxoMir 002; (ii) 1.2% agarose gel for the amplified DNA visualization; where well (1) 1 kb Ladder, (2) Amplified DNA of MyxoMir001, (3) Amplified DNA of MyxoMir002. [Click here to view] |
 | Figure 3: Neighbor-Join phylogenetic tree of isolated strain MyxoMir001. [Click here to view] |
3.4. Primary and Secondary Screening for Cellulase Production
The primary screening of MyxoMir001 was done by observing the zone of hydrolysis through the Congo Red-NaCl staining procedure, which showed a positive result [Figure 4]. The secondary screening was done to affirm the enzyme localization through the 5-DNS method. On measuring the absorbance at 550 nm, the highest absorbance was recorded for the supernatant. This confirms the enzyme to be extra-cellular. Another study reported the utilization of the Congo-red staining and NaCl destaining procedures for the preliminary determination of cellulase production. In this study, isolated cellulase-producing strains from the Boniyar region of Kashmir were screened for cellulase production by this method [30].
| Figure 4: 1% CMC-agar plate inoculated with MyxoMir001 showing zone of hydrolysis. [Click here to view] |
3.5. Biochemical Characterization of Cellulase Enzyme
3.5.1. Determination of optimum temperature
The optimum temperature was determined by following the standard DNS method at different temperatures ranging from 30 to 60°C, following the quantification according to the standard glucose curve. The highest activity of the enzyme was accorded at an optimum temperature of 40°C [Figure 4]. This shows that MyxoMir001 is mesophilic. Iizuka et al. also reported about the myxobacterial strains isolated from hot springs, which showed their optimum growth within the temperature range of 45–49°C [43]. Gerth and Müller have also reported the high morphogenesis of myxobacterial strain between the temperature range of 42–48°C [44]. In addition, Mohr et al. reported that Nannocystis konarekensis isolated from the soil of the Iranian desert showed optimal growth at 37°C in comparison to other species such as Nannocystis pusilla and Nannocystis exedens, which have been reported to show optimal growth at 30°C [45]. The reports support the mesophilic nature of myxobacterial strains. Zhang et al. [39] have reported the optimum growth of M. virescens, M. fulvus, and Corallococcus coralloides within the temperature range of 10–37°C. Whereas Cystobacteria spp. strain xj9-1 showed growth within the temperature range of 10–37°C [39]. In a study, Kim et al. [46] determined the optimal temperature to be 60°C for Myxobacteria fulvus exhibiting effective proteolytic activity [46].
3.5.2. Determination of optimum pH
The optimum pH was determined according to the standard DNS method by assessing the enzyme activity at different pH values from 5 to 12. The maximum activity was observed at an optimum pH of 7.0 [Figure 5]. Myxococcus, Archangium, and Sorangium spp. have been reported to be isolated from bogs at alkaline pH [35]. Moreover, published literature has stated that myxobacteria primarily inhabit slightly alkaline or neutral pH soil, i.e., within the range of 6.5–8.5 [34]. In a study, Kim et al. determined the optimal pH to be within the range of pH 5–10 of M. fulvus exhibiting effective proteolytic activity [46]. Another study reported about lysozyme activity of GH19 glycoside hydrolase obtained from Corallococcus silvisoli c25j21, which showed optimum activity within the pH ranging from 4.5 to 5.0 [47]. Sharma et al. [48] reported about extra-cellular alkaline protease produced by Pyxidicoccus spp. strain S252 which showed optimum activity within the pH range of 11.0–12.0 [48].
 | Figure 5: Biochemical characterization of cellulase produced by MyxoMir001. (a) Optimum temperature and (b) Optimum pH. [Click here to view] |
4. CONCLUSION
Myxobacterial formation of fruiting bodies, spores, social lifestyle, predation, and high G+C content has made it the microbe of interest for obtaining natural compounds. Unexplored environments in tropical areas like the Wetland of the Union Territory of Jammu and Kashmir may contain novel and rare myxobacterial strains. The mesophilic strain of myxobacteria showing cellulolytic activity has been isolated from Mirgund, Jammu and Kashmir. Further, the cellulase enzyme produced by the myxobacterial strain, i.e., MyxoMir001, showed optimum activity at 40°C and pH 7.0. Due to the cellulase-producing ability, this strain of myxobacteria can be used in consortium with Saccharomyces cerevisiae and microbial strains involved in biofuel production, especially bioethanol. It can also be modified through genetic engineering techniques to achieve effective functionality in harsh conditions so that enzymes can be used for a wide range of applications in industries. In the future, the isolated strain of myxobacteria will be studied to produce secondary metabolites (antimicrobial, antioxidant, and cytotoxic potential). In addition, the secondary metabolite extracts will be analyzed by HPLC-MS and NMR to detect new compounds.
5. ACKNOWLEDGMENTS
The authors thank the University for providing the necessary resources and equipment.
6. AUTHOR CONTRIBUTIONS
Conceptualization: Reena Singh, Joginder Singh; formal analysis and investigation: Daljeet Singh Dhanjal.; data collection: Daljeet Singh Dhanjal; Vijay Kumar, Simranjeet Singh writing-original draft preparation: Atif Khurshid Wani; review and editing: Chirag Chopra, Praveen C Ramamurthy; and supervision: Reena Singh.
7. FUNDING
Dr. Simranjeet Singh would like to acknowledge DBT HRD Project & Management Unit, Regional Centre for Biotechnology, NCR Biotech Science Cluster, Faridabad, Haryana, for Research Associateship (DBT-RA), funding under award letter No DBT-RA/2022/July/N/2044 dated January 12, 2023.
8. CONFLICT OF INTERESTS
The authors do not express any competing interest in the work done and the manuscript writing.
8. ETHICAL APPROVALS
This study does not involve experiments on animals or human subjects.
9. DATA AVAILABILITY
All the data generated and analyzed are included in this research article.
10. PUBLISHER’S NOTE
This journal remains neutral with regard to jurisdictional claims in published institutional affiliation.
REFERENCES
1. Khan RA. Natural products chemistry:The emerging trends and prospective goals. Saudi Pharm J 2018;26:739-53. [CrossRef]
2. Volesky B, Luong JH, Aunstrup K. Microbial enzymes:Production, purification, and isolation. Crit Rev Biotechnol 1984;2:119-46. [CrossRef]
3. Singh R, Kumar M, Mittal A, Mehta PK. Microbial enzymes:Industrial progress in 21st century. 3 Biotech 2016;6:174. [CrossRef]
4. Pham JV, Yilma MA, Feliz A, Majid MT, Maffetone N, Walker JR, et al. A review of the microbial production of bioactive natural products and biologics. Front Microbiol 2019;10:1404. [CrossRef]
5. Demain AL, Sanchez S. Microbial drug discovery:80 years of progress. J Antibiot (Tokyo) 2009;62:5-16. [CrossRef]
6. Kumar S, Yadav AK, Chambel P, Kaur R. Molecular and functional characterization of myxobacteria isolated from soil in India. 3 Biotech 2017;7:112. [CrossRef]
7. Thakur P, Chopra C, Dhanjal DS, Chopra RS. Exploring the potential of myxobacteria from Himachal region for antimicrobial activity. Res J Pharm Technol 2017;10:2628-32. [CrossRef]
8. Garcia R, Müller R. Metagenomic approach for the isolation and cultivation of cellulosedegrading myxobacteria. Philipp J Syst Biol 2020;14:1-10. [CrossRef]
9. Thakur P, Chopra C, Anand P, Dhanjal DS, Chopra RS. Myxobacteria:Unraveling the potential of a unique microbiome niche. In:Singh J, Sharma D, Kumar G, Sharma NR, editors. Microbial Bioprospecting for Sustainable Development. Singapore:Springer;2018. 137-63. [CrossRef]
10. Herrmann J, Fayad AA, Müller R. Natural products from myxobacteria:Novel metabolites and bioactivities. Nat Prod Rep 2017;34:135-60. [CrossRef]
11. Shrivastava A, Sharma RK. Myxobacteria and their products:Current trends and future perspectives in industrial applications. Folia Microbiol (Praha) 2021;66:483-507. [CrossRef]
12. Plaza A, Garcia R, Bifulco G, Martinez JP, Hüttel S, Sasse F, et al. Aetheramides A and B, potent HIV-inhibitory depsipeptides from a myxobacterium of the new genus “Aetherobacter“. Org Lett 2012;14:2854-7. [CrossRef]
13. Gemperlein K, Rachid S, Garcia RO, Wenzel SC, Müller R. Polyunsaturated fatty acid biosynthesis in myxobacteria:Different PUFA synthases and their product diversity. Chem Sci 2014;5:1733-41. [CrossRef]
14. Garcia R, Pistorius D, Stadler M, Müller R. Fatty acid-related phylogeny of myxobacteria as an approach to discover polyunsaturated omega-3/6 fatty acids. J Bacteriol 2011;193:1930-42. [CrossRef]
15. Gawas D, Garcia R, Huch V, Müller R. A highly conjugated dihydroxylated C28 steroid from a myxobacterium. J Nat Prod 2011;74:1281-3. [CrossRef]
16. Weissman KJ, Müller R. A brief tour of myxobacterial secondary metabolism. Bioorg Med Chem 2009;17:2121-36. [CrossRef]
17. Sanford RA, Cole JR, Tiedje JM. Characterization and description of Anaeromyxobacter dehalogenans gen. nov., sp. nov., an aryl-halorespiring facultative anaerobic myxobacterium. Appl Environ Microbiol 2002;68:893-900. [CrossRef]
18. Garcia R, Müller R. Simulacricoccus ruber gen. nov., sp. nov., a microaerotolerant, non-fruiting, myxospore-forming soil myxobacterium and emended description of the family Myxococcaceae. Int J Syst Evol Microbiol 2018;68:3101-10. [CrossRef]
19. Garcia RO, Krug D, Müller R. Chapter 3. Discovering natural products from myxobacteria with emphasis on rare producer strains in combination with improved analytical methods. Methods Enzymol 2009;458:59-91. [CrossRef]
20. Garcia R, Stadler M, Gemperlein K, Müller R. Aetherobacter fasciculatus gen. nov., sp. nov. and Aetherobacter rufus sp. nov., novel myxobacteria with promising biotechnological applications. Int J Syst Evol Microbiol 2016;66:928-38. [CrossRef]
21. Iizuka T, Jojima Y, Hayakawa A, Fujii T, Yamanaka S, Fudou R. Pseudenhygromyxa salsuginis gen. nov., sp. nov., a myxobacterium isolated from an estuarine marsh. Int J Syst Evol Microbiol 2013;63:1360-9. [CrossRef]
22. Ojika M, Inukai Y, Kito Y, Hirata M, Iizuka T, Fudou R. Miuraenamides:Antimicrobial cyclic depsipeptides isolated from a rare and slightly halophilic myxobacterium. Chem Asian J 2008;3:126-33. [CrossRef]
23. Diez J, Martinez JP, Mestres J, Sasse F, Frank R, Meyerhans A. Myxobacteria:Natural pharmaceutical factories. Microb Cell Fact 2012;11:52. [CrossRef]
24. Gaspari F, Paitan Y, Mainini M, Losi D, Ron EZ, Marinelli F. Myxobacteria isolated in Israel as potential source of new anti-infectives. J Appl Microbiol 2005;98:429-39. [CrossRef]
25. Kuhad RC, Gupta R, Singh A. Microbial cellulases and their industrial applications. Enzyme Res 2011;2011:280696. [CrossRef]
26. Sethi S, Datta A, Gupta BL, Gupta S. Optimization of cellulase production from bacteria isolated from soil. ISRN Biotechnol 2013;2013:985685. [CrossRef]
27. Rayment GE, Higginson FR. Australian Laboratory Handbook of Soil and Water Chemical Methods. Melbourne:Inkata Press Pvt Ltd.;1992.
28. Green MR, Sambrook J. Isolating DNA from gram-negative bacteria. Cold Spring Harb Protoc 2017;2017:83-4. [CrossRef]
29. Tamura K, Stecher G, Kumar S. MEGA11:Molecular evolutionary genetics analysis version 11. Mol Biol Evol 2021;38:3022-7. [CrossRef]
30. Kaur S, Dhanjal S, Singh DS, Chopra C, Chopra RS. Isolation and biochemical characterization of an alkalophilic, cold-active cellulase from bacteria isolated from Boniyar Region of Kashmir. Plant Arch 2020;20:2548-53.
31. Lokapirnasari WP, Nazar DS, Nurhajati T, Supranianondo K, Yulianto AB. Production and assay of cellulolytic enzyme activity of Enterobacter cloacae WPL 214 isolated from bovine rumen fluid waste of Surabaya abbatoir, Indonesia. Vet World 2015;8:367-71. [CrossRef]
32. Anwar A, Dhanjal DS, Singh R, Chopra C. Isolation and biochemical characterization of an acidophilic, detergent-stable amylase-producing strain of Providencia rettgeri from the soil of Patnitop region, J&K. Res J Pharm Technol 2020;13:5958-62. [CrossRef]
33. Shimkets LJ, Dworkin M, Reichenbach H. The myxobacteria. In:Dworkin M, Falkow S, Rosenberg E, Schleifer KH, Stackebrandt E, editors. The Prokaryotes. New York:Springer;2006. p 31-115. [CrossRef]
34. Mohr KI. Diversity of myxobacteria-we only see the tip of the iceberg. Microorganisms 2018;6:84. [CrossRef]
35. Hook LA. Distribution of myxobacters in aquatic habitats of an alkaline bog. Appl Environ Microbiol 1977;34:333-5. [CrossRef]
36. Rückert G. Beiträge zur Verbreitung, Verbreitungsökologie und Ökologie der Myxobakterien (Myxobacteriales). (Doctoral Thesis);1980.
37. Dawid W. Biology and global distribution of myxobacteria in soils. FEMS Microbiol Rev 2000;24:403-27. [CrossRef]
38. Quinlan MS, Raper KB. Development of the myxobacteria. In:Lang A, editors. Differentiation and Development. Encyclopedia of Plant Physiology. Vol. 15. Berlin, Heidelberg:Springer;1965. 596-611. [CrossRef]
39. Zhang X, Yao Q, Cai Z, Xie X, Zhu H. Isolation and identification of myxobacteria from saline-alkaline soils in Xinjiang, China. PLoS One 2013;8:e70466. [CrossRef]
40. Zhang YQ, Li YZ, Wang B, Wu ZH, Zhang CY, Gong X, et al. Characteristics and living patterns of marine myxobacterial isolates. Appl Environ Microbiol 2005;71:3331-6. [CrossRef]
41. Wu Y, Jiang Y, Kaiser D, Alber M. Social interactions in myxobacterial swarming. PLoS Comput Biol 2007;3:e253. [CrossRef]
42. Hasegawa M, Kishino H, Yano TA. Dating of the human-ape splitting by a molecular clock of mitochondrial DNA. J Mol Evol 1985;22:160-74. [CrossRef]
43. Iizuka T, Tokura M, Jojima Y, Hiraishi A, Yamanaka S, Fudou R. Enrichment and phylogenetic analysis of moderately thermophilic myxobacteria from hot springs in Japan. Microbes Environ 2006;21:189-99. [CrossRef]
44. Gerth K, Müller R. Moderately thermophilic Myxobacteria:Novel potential for the production of natural products isolation and characterization. Environ Microbiol 2005;7:874-80. [CrossRef]
45. Mohr KI, Moradi A, Glaeser SP, Kämpfer P, Gemperlein K, Nübel U, et al. Nannocystis konarekensis sp. nov., a novel myxobacterium from an iranian desert. Int J Syst Evol Microbiol 2018;68:721-9. [CrossRef]
46. Kim JY, Chung JW, Cho KY, Yi YS. Isolation and charaterization of myxobacteria with proteolytic activity. Korean J Microbiol Biotechnol 2009;37:183-8.
47. Li Y, Zhou X, Zhang X, Xu Z, Dong H, Yu G, et al. A myxobacterial GH19 lysozyme with bacteriolytic activity on both Gram-positive and negative phytopathogens. AMB Express 2022;12:54. [CrossRef]
48. Sharma S, Kumar S, Kaur R, Kaur R. Multipotential alkaline protease from a novel Pyxidicoccussp. 252:Ecofriendly replacement to various chemical processes. Front Microbiol 2021;12:722719. [CrossRef]